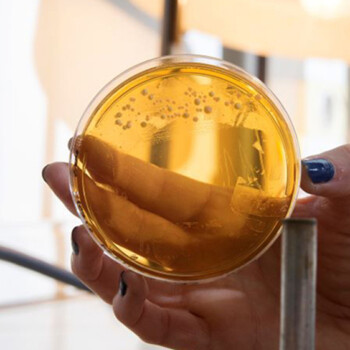

La agricultura regenerativa promueve el uso de técnicas sostenibles que mejoran la calidad del suelo y a diferencia de la agricultura convencional, este sistema buscar aprovechar de manera estratégica los procesos naturales, lo que permite reducir entre 40 y 50% los costos de producción, según especialistas del Instituto Nacional de Tecnología Agropecuaria (INTA) consultados por Télam.
Este sistema, implementado en 1 de cada 50 establecimientos rurales del país, mejoró los ingresos de los agricultores hasta un 30% por haber aplicado prácticas como la diversificación, la reducción de insumos externos, y canales de comercialización alternativos, repercutiendo en alimentos más nutritivos para los consumidores.
“En varios de los ensayos que realizamos pudimos demostrar que con un manejo agroecológico es posible reducir costos, aumentar la rentabilidad y minimizar el impacto ambiental, sustituimos insumos químicos y energía con procesos naturales que permiten ahorrar entre un 40 y un 50% en el costo directo total, con el mismo, o mejor rendimiento”, precisó el referente nacional de Agroecología del INTA, Martín Zamora.
Además, según la Organización de las Naciones Unidas para la Alimentación y la Agricultura (FAO), los enfoques agroecológicos mejoraron los ingresos de los agricultores hasta un 30% gracias a la diversificación, la reducción de insumos externos, y canales de comercialización alternativos, además, destaca la producción local y regional, señaló un informe del organismo multilateral.
De esta manera, 1 de cada 50 establecimientos rurales del país, mejoran sus ingresos hasta un 30%, apuntando a comercializar alimentos más nutritivos, esto significa que los alimentos cultivados de manera convencional tienen menor calidad nutricional en comparación con los alimentos cultivados de forma regenerativa.
Más allá de lo novedoso de la información, lo concreto es que este modelo no es reciente ya que desde los años 70 se implementa en diversos países -entre ellos Argentina- y se basa en prácticas agroecológicas que buscan conservar y revitalizar los procesos biológicos del suelo en el sector agrícola.
Si bien no hay una definición consensuada acerca del término, desde el INTA es comprendida como un sistema productivo basado en la agroecología que implica la reducción de agroquímicos en los suelos, repercutiendo positivamente en los alimentos.
“Tomamos como partida la definición de la FAO como una ciencia que considera un enfoque diferente de producir alimentos, basado en el cuidado del ambiente, de la biodiversidad, inclusive el no uso de agroquímicos. Además, cuenta con principios específicos que implican la transición de un sistema agroecológico industrial al agroecológico”, precisó Zamora.
El especialista detalló que estos principios son la diversidad, sinergias, eficiencia, reciclaje, resiliencia, gobernanza responsable, intercambio de conocimiento, valores humanos-sociales-culturales y tradición alimentaria y economía circular y solidaria.
“En el 2010 comenzamos a trabajar este sistema aumentando la biodiversidad y partiendo de una agricultura distinta, se habla de resiliencia porque debe regenerar condiciones que se han perdido por la agricultura industrial”, dijo.
Entre ellas mencionó la materia orgánica del suelo, la fertilidad del suelo, los microorganismos del suelo, la biodiversidad de plantas, de aves, de roedores, y mamíferos, “que se han perdido por el gran uso de la intensificación agrícola”.
Agroquímicos
Respecto a la utilización de agroquímicos, Rodolfo Gil, otro especialista, sostuvo que no solo garantiza una mayor calidad en los sistemas productivos agroalimentarios, sino que también ofrece beneficios significativos a los agricultores por los costos de estos productos.
“Es importante controlar las plagas, pero más que controlarlas es más importante manejarlas y para eso también hay estrategias que no dependen solamente de un producto que controle la plaga”, afirmó Gil.
Entre las estrategias, mencionó la rotación de cultivos para acortar los ciclos, la intensificación o cultivos de servicio que compiten con las malezas.